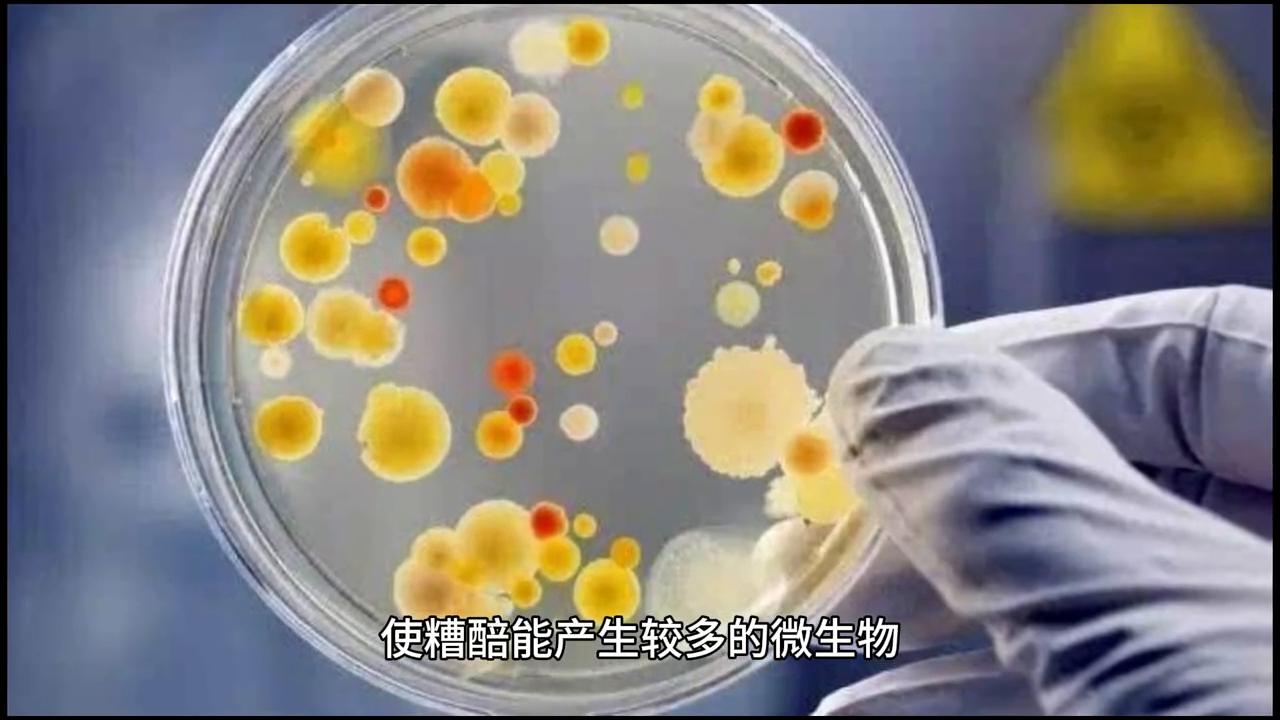
蒸汽出酒率低怎么解决,酿酒出酒率低是什么原因

冬天酿酒如何保温?
冬天出酒率低如何解决?白酒酿造是一个微生物生长代谢的过程,微生物对温度特别敏感,所以温度控制对白酒生产非常重要。如果发酵温度控制不好,产酒率低就是必然的。发酵温度控制在18-28°C是比较合适的。
在冬天难以改变环境温度的情下,固态酿酒要做好糟醅的保温工作。缸桶等容器可以加保温层,地缸则可以盖上棉被等减缓温度散失。条件好的可以采用恒温室发酵,这样发酵所需的时间和发酵的产量都是动态平衡的,处于一个很小的变动范围之内,不会因为温度的变化而影响发酵。

冬季酒曲如何使用?因为冬天的温度比较低,糟醅升温比较慢,有时候温度还达不到发酵的温度,所以在下曲时可以使用多一点的酒曲。具体方法是根据酒曲的使用说明书,取使用酒曲的最大使用量,使糟醅能产生较多的微生物,保证发酵温度提高冬季糟醅的产酒率。

同时箱温在35°C时下曲发酵,这样可大大缩短发酵周期,减少配糟用量。通过配糟能够调整糟醅的淀粉浓度、酸度和温度,也提高了酒糟中残余淀粉的利用和白酒香气,对发酵的稳定性提升白酒出酒率和酒质都有帮助。
适当减少配糟用量,在糖化时可以提高升温速度,以保证糖化的正常进行。糖化做箱时增加堆积厚度,培菌糖化时的堆积厚度应根据气温的变化而变化。夏季要堆得薄,冬季要堆得厚。一般来说夏季堆箱厚度10-15cm,冬季30-40cm。糖化堆积厚度需根据气温适时调整。

总之冬季白酒生产时,注意做好相应的升温保温工作,随时关注酒醅温度变化,并根据实际情况做相应的调整,糟醅的出酒率和白酒品质也能保持较好。